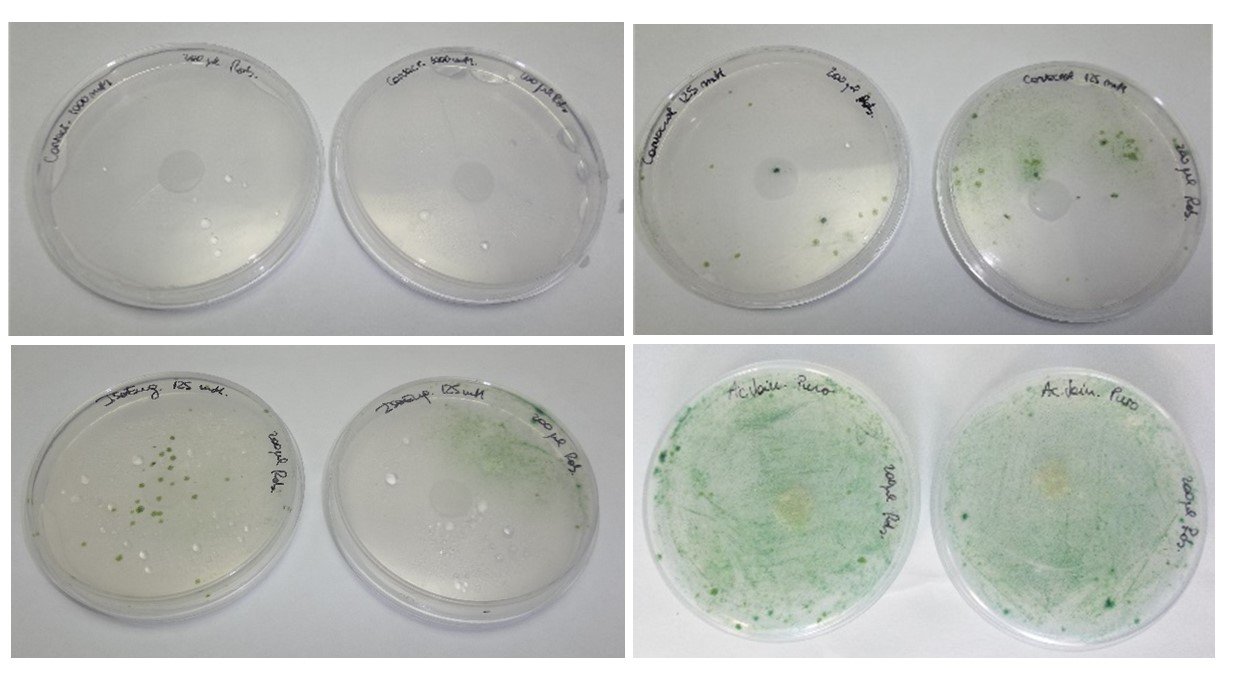
figura3
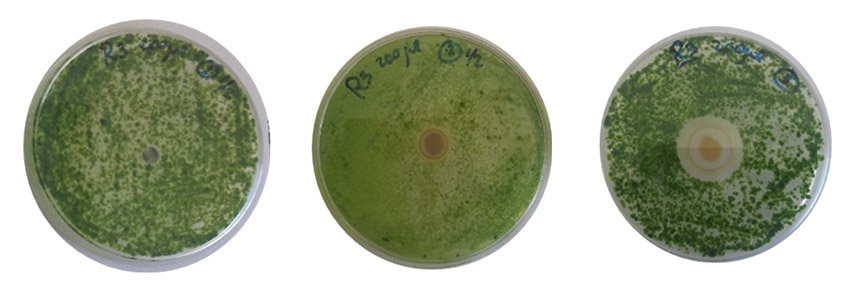
figura4

Bioensayos para la evaluación de la actividad alguicida de pinturas
Silvia Elena Rastelli, Sandra Gómez de Saravia y Marisa Viera CIDEPINT *
Nota publicada en REC 55, marzo 2024
Los organismos fototróficos, como las cianobacterias y las algas, pueden vivir sobre paredes exteriores pintadas de construcciones edilicias, formando biopelículas que deterioran la pintura. Para contrarrestar estos efectos suelen emplearse pinturas con diferentes componentes biocidas que evitan el crecimiento de los mismos. En nuestro laboratorio llevamos a cabo ensayos para evaluar la actividad algicida de diferentes compuestos puros, así como incorporados en pinturas y recubrimientos.
Obtención de organismo target
La actividad algicida en pinturas se evalúa mediante la prueba de biorresistencia, según la especificación estándar de la Sociedad Estadounidense de Pruebas y Materiales (ASTM) D5589-97. Según esta norma, los ensayos se pueden llevar a cabo con cepas de colección recomendadas (Fig.1) o a partir de una muestra ambiental.
Para este último caso, se toma una muestra de una pared pintada expuesta a condiciones ambientales que presente signos de colonización biológica y biodeterioro raspando con bisturí estéril un área determinada y se coloca en un recipiente estéril (Fig.2.a). La muestra se transporta inmediatamente al laboratorio donde se transfiere a caldo BG11, un medio de cultivo líquido específico para el crecimiento y mantenimiento de algas. En el laboratorio, utilizando un microscopio óptico se procede a la identificación de los taxones presentes en la comunidad algal, empleando bibliografía especializada (Fig. 2.b).

Figura 1. Fotografía tomada con microscopio óptico del alga verde unicelular Scenedesmus vacuolatus (perteneciente a la Clase Chlorophyta), una de las cepas mencionadas en la norma ASTM 5589-97

Figura 2: a) Pared con pátina biológica y signos de biodeterioro y toma de muestra. b) Foto de microscopio óptico de la comunidad algal identificada.
Bioensayos para la evaluación de compuestos con potencial actividad algicida
La actividad algicida de un compuesto puede evaluarse mediante diferentes técnicas, según las características del compuesto a estudiar:
- Método de microatmósfera
Es utilizado para compuestos volátiles, como por ejemplo aceites esenciales. Para ello, a partir de un cultivo de algas de 7 días de crecimiento en medio líquido BG11 con una concentración de aprox. 10⁵ algas ml⁻¹, se siembran 200 µl y se extienden uniformemente en una caja de Petri con agar BG11. En el centro de la tapa de la placa de Petri, se coloca un disco estéril de papel de filtro de 13 mm de diámetro que se carga con 50 µl del compuesto a ensayar en estado puro o diluido en la concentración deseada en solvente adecuado, dependiendo de la solubilidad del compuesto.
Las cajas de Petri se cierran de manera invertida, y se sellan con un film termoplástico. Luego se incuban en condiciones de fotoperíodo controlado (16/8 h luz/oscuridad-200 µmol.s.m⁻²) y 25°C durante 28 días. Como control del crecimiento algal se utilizan placas de Petri sin papel de filtro y con papel de filtro humedecido con el solvente empleado, con el fin de descartar la inhibición del crecimiento de algas debido al disolvente. Todas las pruebas se realizan por duplicado.
La actividad inhibidora de los compuestos biocidas sobre las algas se evalúa calculando el porcentaje de cobertura en la cápsula de Petri sembrada y se califica de 0 a 5 con la siguiente escala:
- 0: no hay crecimiento visible evaluado microscópicamente
- 1: crecimiento no visible evaluado a simple vista, pero sí visible microscópicamente
- 2: crecimiento visible a simple vista, cubriendo hasta el 25% de la superficie sembrada
- 3: crecimiento visible a simple vista, cubriendo hasta el 50% de la superficie sembrada
- 4: crecimiento considerable que cubre más del 50% de la superficie sembrada
- 5: crecimiento muy intenso
Para calcular el porcentaje de cobertura se puede emplear algún software de análisis de imágenes como ImageJ. En la Figura 3 se muestran algunos ejemplos de placas con diferente cobertura de crecimiento de la comunidad algal en respuesta a compuestos naturales de origen vegetal ensayados en nuestro laboratorio: carvacrol (1000mM) (Fig.3 a), carvacrol (125 mM) (Fig.3 b), isoeugenol (125 mM) (Fig.3 c), ácido vainillínico (puro) (Fig. 3 d).
Figura 3. Método de microatmósfera, empleado para evaluar la actividad alguicida de un compuesto volátil. Valores de crecimiento algal según escala: a) 0: no hay crecimiento visible evaluado microscópicamente; b) y c) 2: crecimiento visible a simple vista, cubriendo hasta el 25% de la superficie sembrada; y d) 5: crecimiento muy intenso.
2. Método de difusión en placa (o Kirby-Bauer)
Es el método más apropiado para evaluar compuestos no volátiles. En este caso, las placas de Petri con agar BG11 se siembran con el inóculo algal de la forma ya descripta para los compuestos volátiles, pero el disco de papel de filtro estéril es de 6 mm de diámetro y se coloca en el centro del agar sembrado. Sobre el disco, se coloca el compuesto de interés en las concentraciones deseadas y las placas sembradas se incuban bajo las mismas condiciones de fotoperíodo y temperatura.
Luego de 28 días de incubación, se determina la actividad algicida del compuesto según el diámetro de los halos de inhibición, teniendo en cuenta la siguiente escala:
- Sin halo: actividad nula
- Halo ≤ 7mm: actividad biocida baja
- Halo entre 7 y 10 mm: actividad biocida moderada
- Halo > 10 mm: actividad biocida alta
En la Figura 4 pueden observarse diferentes grados de inhibición del crecimiento de la comunidad algal. En esta oportunidad los compuestos ensayados fueron: nanopartículas de plata (NPsAg) (Fig.4 a), nanohíbridos de óxido de grafeno y NPsAg (OG-NPsAg) obtenidos por síntesis ex situ (Fig.4, b) e in situ (Fig. 4, c). Puede verse que los nanohíbridos mostraron actividad algicida, y que esta varió según el método de síntesis empleado.
Figura 4. Resultados de ensayos de difusión en placa: a) actividad biocida nula, b) actividad biocida baja, c) actividad biocida alta.
Bioensayos para la evaluación de la biorresistencia de pinturas con compuestos alguicidas.
Como se mencionó anteriormente, la resistencia de una pintura o recubrimiento al deterioro producido por las algas, según lo indicado en la norma internacional ASTM D5589-97.
Para ello, se aplican tres capas de pintura (en diferentes sentidos) sobre papeles de filtro y se dejan curar el tiempo necesario (según especificaciones de la pintura) a temperatura y humedad ambiente. Luego del curado, el papel de filtro se corta en cuadrados de 2,8 cm de lado y se esterilizan en bajo luz UV. Los cuadrados pintados y esterilizados se inoculan en forma de aerosol con la cepa de colección recomendada o con la comunidad algal en una concentración de aproximadamente 1,4 105 algas ml-1 y se colocan en una placa de Petri con agar BG11. Todas las placas se incuban en condiciones controladas (16/8 h luz/oscuridad, 25°C) durante 28 días. El ensayo se realiza por duplicado.
El crecimiento algal se evalúa en función del porcentaje de cobertura en el papel de filtro según la escala indicada en la mencionada Norma: 0- sin crecimiento; 1- trazas de crecimiento (< 10 %); 2- crecimiento bajo (10-30 %; 3- crecimiento moderado (30-60%); 4- crecimiento elevado (> 60%). En la Figura 5 se muestran resultados de ensayos realizados en nuestro laboratorio, donde se evaluó una formulación de pintura en la que se incorporaron compuestos naturales de origen vegetal como el carvacrol y el isoeugenol, ambos al 2% p/p. El ensayo se realizó empleando la microalga Scenedesmus vacuolatus. Se observa que la incorporación de ambas sustancias otorgó a la formulación empleada capacidad alguicida.

Figura 5. Resultados de un ensayo de biorresistencia empleando una pintura control (a) y la pintura formulada con isoeugenol al 2% p/p (b) y carvacrol al 2% p/p (c). Los resultados indican a) Nivel de cobertura: 4- crecimiento elevado (> 60% de cobertura); b) y c) Nivel de cobertura: 0- sin crecimiento
Silvia Elena Rastelli (1,2)
e.rastelli@cidepint.ing.unlp.edu.ar
Sandra Gómez de Saravia (1,3)
s.gomez@cidepint.ing.unlp.edu.ar
Marisa Viera (1,4)
m.viera@cidepint.ing.unlp.edu.ar
1) Centro de Investigación y Desarrollo en Tecnología de Pinturas y Recubrimientos- CIDEPINT (CONICET-CICPBA- FI, UNLP),
2) Fac. de Cs. Naturales y Museo (UNLP)
3)UNAJ,
4) Fac. Cs. Exactas (UNLP)
